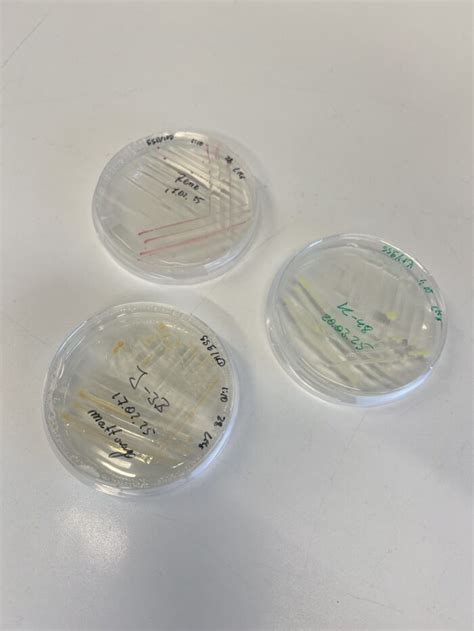

LPSN And DSMZ: Understanding Microbial Nomenclature
LPSN and DSMZ: Understanding Microbial Nomenclature
Understanding the world of microbial nomenclature can be a bit like navigating a maze, right? Two key players that often pop up in this field are the List of Prokaryotic Names with Standing in Nomenclature (LPSN) and the German Collection of Microorganisms and Cell Cultures (DSMZ) . Knowing what these organizations do and how they contribute to naming and classifying bacteria and archaea is super important for anyone working in microbiology, whether you’re a researcher, a student, or just someone curious about the tiny life all around us. So, let’s dive in and break it down in a way that’s easy to understand!
Table of Contents
What is LPSN?
Let’s start with LPSN, which stands for the List of Prokaryotic Names with Standing in Nomenclature . This is basically the official list (or as official as it gets!) of all the bacteria and archaea names that are considered legitimate. Now, you might be thinking, “Why do we even need a list like that?” Well, imagine the chaos if anyone could just name a new bacterium whatever they wanted without any oversight. It would be impossible to keep track of what’s what, and scientific communication would be a nightmare. LPSN steps in to prevent that chaos by maintaining a carefully curated database of names that have met certain criteria.
The criteria for a name to make it onto the LPSN list are laid out in the International Code of Nomenclature of Prokaryotes . This code sets the rules for how new species should be named, described, and validated. When a researcher discovers a new bacterium, they can’t just give it any old name. They have to follow the code, which includes things like publishing a detailed description of the organism, depositing a culture in a recognized culture collection (more on that in a bit!), and proposing a name that follows the established rules of grammar and etymology. Once all of that is done, and the name is published in the International Journal of Systematic and Evolutionary Microbiology (IJSEM) , it can be considered for inclusion in LPSN.
LPSN is more than just a static list of names. It’s a dynamic resource that’s constantly being updated as new species are discovered and as our understanding of microbial relationships evolves. The database includes a wealth of information about each species, such as its taxonomic classification, its type strain (the original strain used to describe the species), and links to relevant publications. This makes it an invaluable tool for anyone trying to identify a bacterium or learn more about its characteristics. LPSN ensures that when scientists around the world refer to a particular bacterium by its scientific name, they’re all talking about the same thing. This is essential for clear communication and collaboration in the field of microbiology.
What is DSMZ?
Now, let’s talk about DSMZ, the German Collection of Microorganisms and Cell Cultures . Think of DSMZ as a giant library, but instead of books, it’s filled with living cultures of bacteria, archaea, fungi, viruses, plant cell cultures, and even human and animal cell lines. It’s one of the largest and most diverse culture collections in the world, and it plays a crucial role in preserving and providing access to microbial resources for research, industry, and education.
One of the key functions of DSMZ is to act as a repository for type strains. Remember how I mentioned that researchers have to deposit a culture of a new species in a recognized culture collection as part of the naming process? Well, DSMZ is one of those recognized collections. When a researcher deposits a type strain at DSMZ, it becomes a permanent reference point for that species. Other researchers can then obtain the strain from DSMZ to compare it to their own isolates, to study its characteristics, or to use it in experiments. This ensures that the scientific community has access to the authentic, well-characterized strains that are essential for reproducible research.
But DSMZ does more than just store and distribute cultures. It also conducts research on microbial diversity, taxonomy, and evolution. The scientists at DSMZ are experts in identifying and characterizing microorganisms, and they use a variety of techniques, including genomics, proteomics, and metabolomics, to study the relationships between different species. This research helps to improve our understanding of the microbial world and to develop new tools for identifying and classifying microorganisms. DSMZ also offers a range of services to the scientific community, such as strain identification, whole genome sequencing, and bioinformatics support. These services can be invaluable for researchers who don’t have the expertise or resources to perform these tasks themselves. For example, imagine you’ve isolated a bacterium from a soil sample, and you want to know what it is. You could send a culture to DSMZ, and they would use their expertise to identify it for you.
The Interplay Between LPSN and DSMZ
So, how do LPSN and DSMZ work together? Well, they have a symbiotic relationship. LPSN relies on culture collections like DSMZ to preserve and provide access to the type strains that are essential for defining species. DSMZ, in turn, benefits from the taxonomic expertise of the researchers who contribute to LPSN. The scientists who describe new species and propose names are often the same ones who deposit the type strains at DSMZ. This close collaboration ensures that the names listed in LPSN are linked to tangible, well-characterized organisms that are available for study.
Think of it like this: LPSN is the official rulebook for naming prokaryotes, and DSMZ is the library where you can find the actual specimens that those names refer to. Both are essential for maintaining order and clarity in the world of microbial nomenclature. When a new species is described, the researcher proposing the name has to deposit a culture in a recognized culture collection like DSMZ. This culture becomes the type strain for that species – essentially, the definitive example of that species. LPSN then records the name and links it to the information about the type strain held at DSMZ. This ensures that scientists around the world can access and study the correct organism when they come across the name in research papers or databases.
The collaboration extends to maintaining accuracy. If there’s ever a question about the identity of a species, researchers can go back to the type strain held at DSMZ for comparison. Advanced techniques like genome sequencing can be used to verify that the strain matches the original description. If discrepancies are found, the name might be reevaluated by the taxonomic community, potentially leading to changes in LPSN to reflect the updated understanding of the species.
Why This Matters
Alright guys, why should you care about all this nomenclature jazz? Well, accurate naming and classification are fundamental to all areas of biology, including microbiology. Without a clear and consistent system for naming organisms, it would be impossible to communicate effectively about them. Imagine trying to discuss the role of Escherichia coli in food poisoning if no one could agree on what to call it! Accurate nomenclature is also essential for tracking the spread of infectious diseases, for developing new antibiotics, and for understanding the evolution of microbial life.
Moreover, the work of LPSN and DSMZ has practical implications. For instance, in biotechnology, knowing the correct name and characteristics of a bacterium is crucial for optimizing its use in industrial processes. In environmental science, accurate identification of microorganisms is essential for monitoring water quality and for bioremediation of polluted sites. In medicine, rapid and accurate identification of pathogens is critical for diagnosing and treating infections. In all of these fields, the information provided by LPSN and the resources provided by DSMZ are essential for making informed decisions.
Conclusion
In conclusion, both the List of Prokaryotic Names with Standing in Nomenclature (LPSN) and the German Collection of Microorganisms and Cell Cultures (DSMZ) are very important for the field of microbiology. LPSN provides the official list of prokaryotic names, ensuring standardization and clarity in scientific communication. DSMZ acts as a crucial repository for microbial cultures, preserving type strains and providing access to valuable resources for research and other applications. Together, they help to ensure that the world of microbial nomenclature remains organized, accurate, and accessible to all.
So, the next time you stumble upon a funky bacterial name, remember the unsung heroes at LPSN and DSMZ who work tirelessly to keep the microbial world neatly labeled and ready for exploration. Understanding their roles is key to unlocking the vast potential hidden within these tiny organisms!